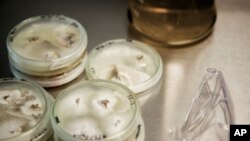
انسانی اسٹم سیل پر تحقیق کے لیے فنڈز فراہم کرنے کی اجازت

امریکہ کی ایک اپیل کورٹ نےاوباما انتظامیہ کوسابق عدالتی فیصلہ تبدیل کرتے ہوئے اسٹم سیل کی تحقیق کے لیے فنڈز فراہم کرنے کی اجازت دے دی ہے۔
عدالت کے تین رکنی پینل نے جمعے کے روز اپنے فیصلےمیں کہا کہ اسٹم سیل کی تحقیق کے لیے فنڈز کی فراہمی امریکہ کے موجودہ قوانین کی خلاف ورزی نہیں ہے۔
ایک کے مقابلے میں دو ججوں کے فیصلے سے گذشتہ سال ہونے والا ایک وفاقی جج کا وہ فیصلہ مؤثر نہیں رہا جس میں انہوں نے ایک اپیل کی سماعت میں اسٹم سیل کی تحقیق کےلیےفنڈز فراہم کرنے کی مخالفت کی تھی۔
فیصلے سے تحقیق کے لیے حکومت کی جانب سےعارضی طورپر فنڈز کو روک دیا گیا تھا، تاہم اپیل کورٹ کی جانب سے سماعت شروع ہونے پر اِس حکم پرعمل درآمد معطل ہوگیا تھا اور فنڈز فراہم ہونا شروع ہوگئے تھے۔ ریسرچرز، جنہوں نے ابتدائی اپیل دائر کی تھی، وہ اب بھی سپریم کورٹ میں جاسکتے ہیں۔
امریکی صدر اوباما بچے کی پیدائش کے ابتدائی عرصے کے اسٹم سیل، جسے جنین کہا جاتا ہے، تحقیق کے حق میں ہیں اور انہوں نے اِس سے متعلق پراجیکٹس کی رقوم میں اضافہ کردیا تھا۔
اِس تحقیق کے لیے خلیے اُس انسانی جنین سے حاصل کیے جاتے جِس کی عمر محض چندروز ہوتی ہے اور اُن کا اسقاط ہوچکا ہوتا ہے۔ اِن خلیوں کو انسانی جسم کے اندر کسی بھی طرح کے خلیے پیدا کرنے لیے استعمال کیا جاتا ہے۔
تحقیق کے حامیوں کا کہناہے کہ اس ریسرچ سے کئی امراض کے علاج میں مدد مل سکتی ہے، جب کہ مخالفین کا کہناہے کہ انسانی اسٹم سیل سے کچھ اور بنانا غلط ہے کیونکہ اس سے جنین کو نقصان پہنچ سکتا ہے یا وہ ضائع ہوسکتا ہے، جو ان کےخیال میں ایک انسانی زندگی ہی ہوتی ہے۔
صدر اوباما نے اپنا عہدہ سنبھالنے کے کچھ ہی عرصے کے بعد جنین اسٹم سیل کی تحقیق پر آٹھ سال سے نافذ پابندی ختم کرنے کا حکم جاری کیا تھا۔
وہائٹ ہاؤس نے جمعے کے عدالتی فیصلے کو سائنس دانوں اور دنیا بھر میں موجود مریضوں کی فتح قرار دیا ہے۔